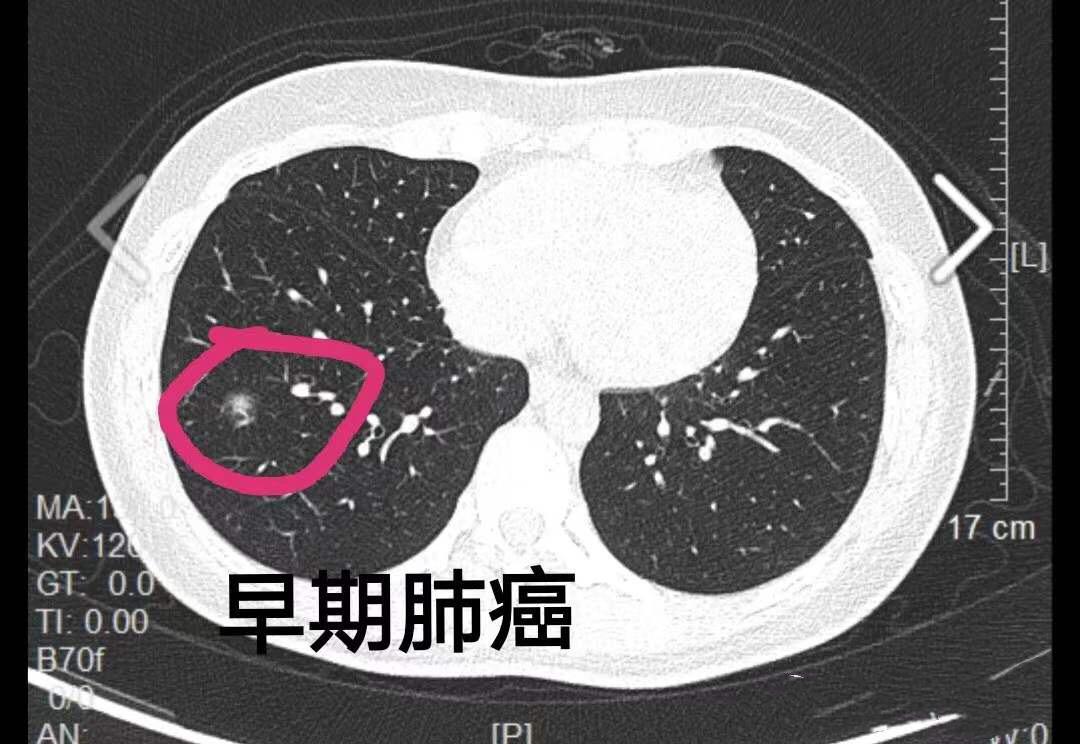

随着新官肺炎的最新消息逐渐明朗,我们的生活开始逐渐回归正轨,在这个充满挑战的时期,我们不妨将目光转向自然,探索那些远离尘嚣的美景,寻找内心的平静与宁静的力量,让我们一起踏上这场鼓舞人心的旅程,让心灵在自然美景中得到洗涤和放松。
笑对困境,启程寻梦
新官肺炎虽然给我们带来了诸多困扰,但正如一句老话所说:“困难是暂时的,而快乐是无限的。”在这个特殊的时期,我们不妨以乐观的心态面对挑战,带上背包和相机,踏上探索自然美景的旅程,让我们在旅途中发现那些被忽视的美好,用笑声和勇气面对困境。
远离尘嚣,拥抱自然
当我们走进大自然,远离城市的喧嚣和繁忙,我们会发现内心的平静正在悄然回归,阳光、绿树、鸟鸣和微风,这些自然元素为我们带来无尽的愉悦和放松,让我们在这个特殊的时刻,放慢脚步,深呼吸清新的空气,感受大自然的美好。
发现内心平静的力量
自然美景不仅让我们心情愉悦,更能让我们发现内心的平静与力量,当我们置身于大自然中,我们会发现生活中的烦恼和压力逐渐消散,取而代之的是内心的宁静和满足,这种力量让我们更加坚定地面对生活中的挑战,以乐观的心态迎接未来。
幽默元素加持,轻松面对一切
在这场自然之旅中,不妨加入一些幽默元素,让旅程更加轻松愉快,当我们遇到困难和挑战时,不妨以幽默的态度面对,将困境转化为乐趣,这样,我们不仅能够轻松应对挑战,还能在旅途中收获更多的欢笑和美好回忆。
新官肺炎时期下的安全旅行
虽然新官肺炎的最新消息逐渐明朗,但我们仍然需要保持警惕,在踏上自然之旅的过程中,我们要遵守当地的防疫规定,保持社交距离,佩戴口罩,勤洗手等,这样,我们既能享受旅行的乐趣,又能保障自己和他人的安全。
鼓励观众踏上旅程
不要等待新官肺炎完全过去才踏上旅程,正是我们探索自然美景、发现内心平静的好时机,让我们在这个特殊的时期,勇敢踏上旅程,感受大自然的魅力,无论你是独自旅行还是与朋友结伴,都能在这场自然之旅中找到乐趣和力量。
新官肺炎虽然给我们带来了诸多困扰和挑战,但我们仍然可以用乐观的心态面对生活,让我们在探索自然美景的旅程中,发现内心的平静与力量,让我们在旅途中笑对困境,用幽默的态度面对挑战,让我们在遵守防疫规定的前提下,勇敢踏上旅程,感受大自然的魅力,相信我们一定能够在这次旅行中找到内心的宁静与平和。

京公网安备11000000000001号
京公网安备11000000000001号 京ICP备11000001号
京ICP备11000001号